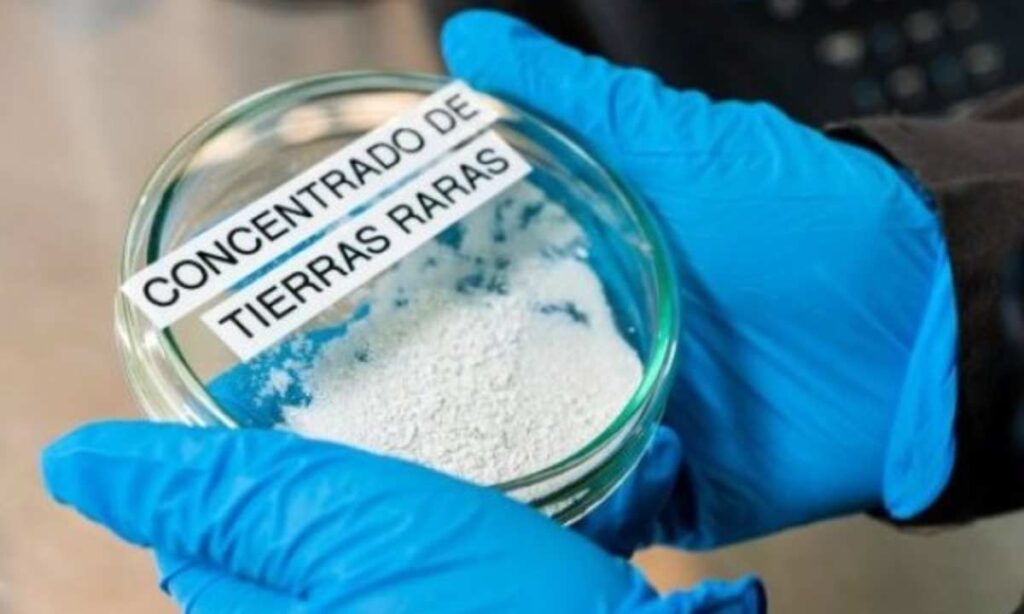

Aclara Resources Inc. (TSX:ARA) anunció su decisión de construir la primera instalación de separación de tierras raras pesadas (HREE) en Estados Unidos, ubicada en Luisiana, con alimentación sostenible esperada de depósitos de arcilla iónica en Brasil y Chile. El proyecto se prevé finalice en 2027, sujeto a acuerdos de financiación y compra, y se espera que los depósitos estén operativos a mediados de 2028.
La planta producirá disprosio (Dy), terbio (Tb) y otros HREE restringidos, así como tierras raras ligeras (LREE), esenciales para tecnologías avanzadas como vehículos eléctricos, turbinas eólicas, drones y robótica. Una vez en operación plena, Aclara prevé abastecer más del 75% de los requerimientos estadounidenses de DyTb para vehículos eléctricos.
Se estima una producción anual de 200 tpy de Dy, 30 tpy de Tb y 1.400 tpy de NdPr, equivalente a aproximadamente 14% de la producción oficial de DyTb de China. El estado de Luisiana apoyará el proyecto con US$46,4 millones en incentivos fiscales y subvenciones, en un sitio de 82 acres en el Puerto de Vinton con acceso directo por carretera y vía fluvial.
Participación clave de Chile y Brasil
Aclara desarrollará también una planta de metales y aleaciones para apoyar la industria de imanes permanentes de alto rendimiento y ha contratado a Hatch Ltd. para la ingeniería del proyecto, coordinando con su Proyecto Carina en Brasil para optimizar eficiencia y cronogramas.
La compañía colabora con Virginia Tech para validar su proceso de separación patentado mediante una planta piloto, que se espera opere plenamente en el primer trimestre de 2026, acumulando 1,5 años de datos operativos antes del inicio de la planta de Luisiana.
La integración con los depósitos de arcilla iónica de Brasil y Chile garantiza producción confiable de HREE y una ventaja competitiva en minería y separación. Se anticipa la publicación del Estudio de Prefactibilidad (PFS) de Carina a principios de noviembre de 2025 y el Estudio de Factibilidad (FS) en el segundo trimestre de 2026.
Desarrollo para establecer un suministro confiable de estos minerales críticos
La secretaria del LED, Susan B. Bourgeois, comentó que “la inversión de Aclara subraya la importancia de contar con sitios listos para el desarrollo y sólidas alianzas locales que brindan a las empresas globales la confianza para elegir Luisiana”.
Mientras tanto, el director ejecutivo de Aclara, Ramón Barua, sostuvo que la “prioridad era identificar una ubicación que permitiera un desarrollo rápido, dada la urgente necesidad de establecer un suministro confiable de estos minerales críticos. La acogida del gobernador Landry y su equipo ha sido excepcional, y el programa LED de Luisiana ofrece precisamente el entorno propicio para la inversión que este sector estratégico requiere”.
Po su parte, el director de operaciones de Aclara, Hugh Broadhurst, indicó que “estas instalaciones se convertirán en un pilar fundamental para la reindustrialización de minerales críticos en el hemisferio occidental”. En tanto, el Dr. Aaron Noble, profesor y jefe del Departamento de Ingeniería de Minas y Minerales de Virginia Tech, comentó que «El liderazgo de Aclara en la extracción y el procesamiento de tierras raras complementa el compromiso de nuestro departamento con el avance tecnológico y la preparación de futuros líderes en la industria minera».
Fuente: Reporte Minero